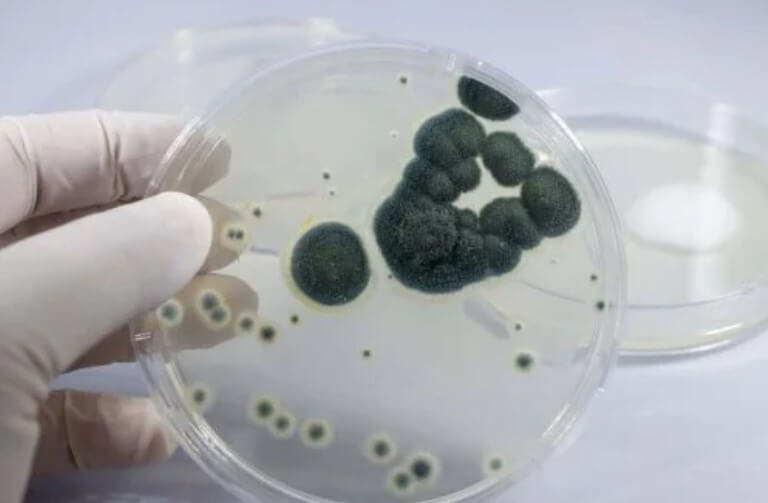

Πενικιλίνη: Ποιες είναι οι χρήσεις της στην ιατρική;


Έχει εξετασθεί και εγκριθεί από: γιατρό Diego Pereira
Η πενικιλίνη είναι ένα αντιβιοτικό φάρμακο που προέρχεται από τον μύκητα Penicillium. Αυτή η μεγάλη ανακάλυψη στον κόσμο της ιατρικής αποδίδεται στον Alexander Fleming, έναν σκωτσέζικο βακτηριολόγο. Ανακάλυψε την πενικιλίνη το 1928. Ωστόσο, οι ειδικοί κατάφεραν να την παράγουν μόνο 10 χρόνια αργότερα. Αυτοί που ήταν υπεύθυνοι για αυτό το έργο ήταν ο βιοχημικός Ernst Boris Chain και ο παθολόγος Howard Florey.
Η πενικιλίνη είναι ένα αντιβιοτικό που ανήκει στην οικογένεια των βήτα-λακταμών (β-λακτάμες). Αυτό το αντιβιοτικό έχει ένα ευρύ φάσμα δράσης και είναι αποτελεσματικό έναντι πολλών διαφορετικών βακτηρίων, όπως πνευμονιόκοκκοι, στρεπτόκοκκοι, Clostridium tetani (που προκαλούν τετάνο) και μηνιγγιτιδόκοκκος, μεταξύ άλλων.
Λέμε ότι ήταν μια καταπληκτική ανακάλυψη στον κόσμο της ιατρικής επειδή, όταν ανακαλύφθηκε, βοήθησε στην εξάλειψη αρκετών ασθενειών που αποδείχτηκαν θανατηφόρες για τους ασθενείς εκείνης της εποχής. Αυτές περιελάμβαναν σήψη, γονόρροια, ακόμη και οστρακιά.
Ωστόσο, οι επαγγελματίες του ιατρικού τομέα έχουν κάνει κατάχρηση της χορήγησης τόσο της πενικιλίνης όσο και των συνθετικών και ημισυνθετικών παραγώγων που έχουν ανακαλυφθεί με την πάροδο του χρόνου. Ως αποτέλεσμα, τα βακτήρια έχουν γίνει ανθεκτικά σε αυτά τα αντιβιοτικά. Αυτό είναι ένα σοβαρό παγκόσμιο πρόβλημα υγείας. Σήμερα, οι ειδικοί συνεχίζουν να ερευνούν νέους μηχανισμούς δράσης και θεραπευτικές εναλλακτικές λύσεις για την καταπολέμηση αυτών των ανθεκτικών βακτηρίων.
Ρίξτε μια ματιά και εδώ: 6 φυσικά αντιβιοτικά τα οποία πιθανώς δεν γνωρίζατε
Τι είναι τα αντιβιοτικά βήτα-λακτάμης;

Σε γενικές γραμμές, αυτός ο τύπος αντιβιοτικών είναι στενού φάσματος, καθώς είναι αποτελεσματικά μόνο κατά των θετικών κατά gram βακτηρίων και σκοτώνουν τα βακτήρια. (Ωστόσο, η πενικιλίνη είναι ευρέος φάσματος).
Αυτά τα φάρμακα χορηγούνται από του στόματος και παρεντερικά. Επίσης, είναι πολύ ασφαλείς επειδή οι πιθανές παρενέργειες περιορίζονται σε αντιδράσεις υπερευαισθησίας. Ωστόσο, αυτές οι αντιδράσεις πρέπει να ελέγχονται, καθώς μπορούν να προκαλέσουν αναφυλακτικό σοκ. Επιπλέον, παρόλο που μπορούν να διασχίσουν τον φραγμό του πλακούντα, οι γιατροί μπορούν να τις υποδείξουν σε έγκυες γυναίκες λόγω του καλού προφίλ ασφάλειας που έχουν δείξει σε κλινικές δοκιμές.
Συνολικά, αυτά τα αντιβιοτικά έχουν πολλές χρήσεις.
Τύποι αντιβιοτικών βήτα-λακτάμης
Μεταξύ των ομάδων που απαρτίζουν αυτήν την οικογένεια αντιβιοτικών, μπορούμε να βρούμε:
- Πενικιλίνη,
- Κεφαλοσπορίνη,
- Μονοβακτάμες, που καταπολεμούν τα αρνητικά κατά gram βακτήρια,
- Καρβαπενέμη.
Μηχανισμός δράσης: Πώς λειτουργεί η πενικιλίνη στο σώμα;
Η πενικιλίνη είναι ένα φάρμακο που σκοτώνει και αναστέλλει την ανάπτυξη βακτηρίων. Για το λόγο αυτό, οι ειδικοί το θεωρούν βακτηριοκτόνο φάρμακο. Ωστόσο, μπορεί να σκοτώσει μόνο μικροοργανισμούς που αναπτύσσονται και πολλαπλασιάζονται και όχι αυτούς που είναι αδρανείς.
Επιπλέον, και όπως αναφέραμε παραπάνω, η πενικιλίνη ανήκει στην ομάδα των αντιβιοτικών β-λακτάμης. Αυτή η οικογένεια φαρμάκων αναστέλλει τη σύνθεση της βακτηριακής δομής των κυτταρικών τοιχωμάτων, η οποία είναι απαραίτητη για τη ζωή των βακτηρίων, για τη θανάτωση αυτών των μικροοργανισμών.
Προς το σκοπό αυτό, αναστέλλει τη διαδικασία τρανσπεπτιδίωσης και, τελικά, αποτρέπει τη σύνθεση πεπτιδογλυκάνης. Συνολικά, το αντιβιοτικό πρέπει να διεισδύσει μέσα στο κύτταρο και, μόλις φτάσει εκεί, να συνδεθεί με τις πρωτεΐνες των πενικιλίνων.
Δείτε ακόμα: Τα καλύτερα φυσικά αντιβιοτικά και πώς τα χρησιμοποιούμε
Ανεπιθύμητες παρενέργειες: αλλεργία στην πενικιλίνη
Αν και η πενικιλίνη είναι σχετικά ασφαλής, μπορεί να προκαλέσει πολλές παρενέργειες. Μεταξύ αυτών, υπάρχει υπερευαισθησία ή αλλεργία στην πενικιλίνη. Αν και αυτή είναι η πιο σημαντική παρενέργεια, η σοβαρότητα ποικίλλει από ασθενή σε ασθενή. Τα συμπτώματα περιλαμβάνουν:
- Επεισόδια με δερματικά εξανθήματα,
- Κνίδωση,
- Αναφυλακτικό σοκ.
Άλλες αντιδράσεις που μπορεί να προκαλέσει αυτό το φάρμακο είναι γαστρεντερικές διαταραχές, όπως διάρροια, ναυτία και έμετος και πρόσθετες λοιμώξεις, όπως καντιντίαση.
Συμπέρασμα
Η ανακάλυψη της πενικιλίνης ήταν μια σημαντική ανακάλυψη στην ιατρική. Αυτό το φάρμακο έχει βοηθήσει στην εξάλειψη πολλών από τις θανατηφόρες ασθένειες της εποχής.
Ωστόσο, η κατάχρηση αυτού του φαρμάκου, καθώς και άλλες ανακαλύψεις, οδήγησε στην ανάπτυξη αντοχής στα αντιβιοτικά. Έτσι, αυτά τα αντιβιοτικά έχουν χάσει σημαντικά την αποτελεσματικότητά τους. Επομένως, υπάρχει ανάγκη για νέα αντιβιοτικά.
Όλες οι παραθέτονται πηγές ελέγχθηκαν προσεκτικά από την ομάδα μας για να διασφαλιστεί η ποιότητα, η αξιοπιστία, η επικαιρότητα και η εγκυρότητά τους. Η βιβλιογραφία αυτού του άρθρου θεωρήθηκε αξιόπιστη και επιστημονικά ακριβής.
- Ligon, B. L. (2004). Penicillin: Its Discovery and Early Development. Seminars in Pediatric Infectious Diseases, 15(1), 52–57. https://doi.org/10.1053/j.spid.2004.02.001
- Kardos, N., & Demain, A. L. (2011, November). Penicillin: The medicine with the greatest impact on therapeutic outcomes. Applied Microbiology and Biotechnology. https://doi.org/10.1007/s00253-011-3587-6
- Lobanovska, M., & Pilla, G. (2017). Penicillin’s discovery and antibiotic resistance: Lessons for the future? Yale Journal of Biology and Medicine, 90(1), 135–145.
- Gaynes, R. (2017). The discovery of penicillin—new insights after more than 75 years of clinical use. Emerging Infectious Diseases, 23(5), 849–853. https://doi.org/10.3201/eid2305.161556
- Macy, E. (2018). Penicillins. In Drug Allergy Testing (pp. 103–113). Elsevier Inc. https://doi.org/10.1016/B978-0-323-48551-7.00010-9
Αυτό το κείμενο προσφέρεται μόνο για ενημερωτικούς σκοπούς και δεν αντικαθιστά τη συμβουλή από επαγγελματία. Σε περίπτωση αμφιβολίας, συμβουλευτείτε τον ειδικό σας.